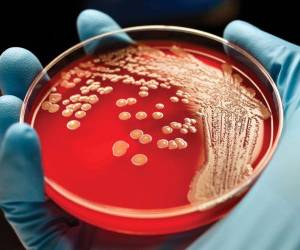

وجود کد سرطان کشی در بدن مارکوس ای پیتر و توماس اسپایس از مدرسه پزشکی فین برگ در ایلینوی به این نکته رسیدهاند که سلولهای بدن قادر به کشتن خودشان هستند؛ چراکه هر سلولی در بدن حاوی یک کد خود نابودگر است که میتواند منجر به تخریب خود شود. یافتن چنین کدی میتواند برای مبارزه با سرطان در آینده مورد …
بیشتر بخوانید »اخبار سرطان
آیا کم کاری تیروئید و پرکاری تیروئید با سرطان ارتباطی دارند؟
سرطان چه ارتباطی با کم کاری و پرکاری تیروئید دارد؟ احتمال ابتلا به سرطان در مبتلایان به کم کاری تیرویید بسیار کم است و در اکثر موارد بیشتر از افراد معمولی نیست. گره تیروئید چیست؟ اکثر گرهها و سرطانهای تیروییدی همراه با کم کاری و پرکاری تیرویید نیستند و در بیشتر این بیماران کار تیرویید طبیعی بوده و آزمایشهای هورمونی …
بیشتر بخوانید »درمان سرطان با داروهای ضد روان پریشی
سلول های سرطانی برخی سلول های سرطانی با وجود کلسترول بالا زنده می مانند. تحقیقات جدید از داروهای آنتی سایکوتیک antipsychotic یا ضد روان پریشی برای نرسیدن کلسترول به این سلول ها و نابود کردنشان استفاده کرده اند. برخی مطالعات نشان داده اند که سرطان های بدخیم خاصی برای ادامه رشدشان به کلسترول نیاز دارند و سرم خونی که کلسترول …
بیشتر بخوانید »مقابله با سلول های سرطانی سه گانه منفی
کشف روش جدیدی برای مقابله با سلول های سرطانی سه گانه منفی پستان در حال حاضر، دانشمندان در موسسه تحقیقاتی لرنر در اوهایو کلینیک ادعا می کنند که آنها مسیر جدیدی از سلول های بنیادی را شناسایی کرده اند که باعث می شود سرطان سینه بسیار خطرناک و سه گانه منفی ایجاد شود. در این مطالعه که در مجله Nature …
بیشتر بخوانید »آشنایی با علائم سرطان مری
در مراحل اولیه سرطان مری، افراد ممکن است با چند نشانه بیماری مواجه شوند. بیشتر علائم به واسطه بزرگ شدن تومور و باریک شدن مری که عبور غذا را دشوار می سازد، شکل می گیرند. مری رابطی بین دهان و معده است. این قسمت از بدن انسان نیز همانند قسمت های دیگر می تواند درگیر بیماری سرطان شود. …
بیشتر بخوانید »درمان سرطان خون کشف شد!
جزئیات کشف درمان سرطان خون سرطان خون یکی از انواع سرطان های کشنده و شایع است که معمولاً از مغز استخوان شروع می شود و باعث شکل گیری تعداد زیادی گلبول سفید غیرطبیعی می گردد.این گلبول های سفید خونی به صورت کامل تشکیل نشده اند و به آنها بلاست یا سلول های لوکمی یا سرطان خون گفته می شود. متاسفانه …
بیشتر بخوانید »ردپای سیگار در بروز 13 سرطان
سیگار موجب بروز۹۰ درصد سرطانهای ریه، ۵۰ درصد بیماریهای قلبی عروقی، ۷۵ درصد بیماریهای تنفسی و ۱۲ درصد کل مرگها و ۳۰ درصد مرگهای بین ۳۰ تا ۵۰ سالگی است. انواع فرآوردههای دخانی شامل سیگار، پیپ، قلیان، تنباکوی جویدنی و سیگار سبب ایجاد سرطان میشوند. برخلاف تصور رایج در جامعه که ناشی از ترفندهای تبلیغاتی صنعت دخانیات است، خطر سرطانزایی …
بیشتر بخوانید »اقداماتی برای کاهش سرطان پروستات
سرطان پروستات مطالعات نشان داده اند مردانی که غذاهایی سرشار از چربی حیوانی، مانند لبنیات و گوشت قرمز، مصرف می کنند، احتمال بیشتری دارد به سرطان پروستات مبتلا شوند. اندیشه درباره ابتلا به سرطان پروستات برای بسیاری از مردان می تواند وحشت آفرین باشد. جدا از سرطان پوست، این شایعترین نوع سرطان در مردان است. مردان بالای 50 سال احتمال …
بیشتر بخوانید »همه چیز در مورد سرطان معده
سرطان معده چیست؟ سرطان معده(gastric cancer) نوعی سرطان است و شایع ترین فرم آن، آدنوکارسینوم یا سرطان غددی در معده است. سرطان معده را می توان رشد بدون کنترل سلول های بدخیم در معده دانست .سرطان معده سالیانه باعث مرگ حدود یک میلیون نفر در سرتاسر جهان می شود. انواع سرطان معده سرطان معده در اکثر موارد از سلولی شروع …
بیشتر بخوانید »سرطان رحم و نکاتی مربوط به آن
سرطان رحم یک سرطان رایج در بین خانم هاست که معمولا بعد از یائسگی بروز می کند. در ادامه به جزئیات بیشتری در مورد سرطان رحم اشاره می شود. سرطان رحم چیست؟ سرطان رحم در واقع یک تومور سرطانی است که در رحم بروز می کند. اکثر خانم ها در غشا رحم یعنی اندومتریوم endometrium دچار این تومور می شوند، …
بیشتر بخوانید » کلینیک مجازی کلینیک من معرفی برترین پزشکان
کلینیک مجازی کلینیک من معرفی برترین پزشکان